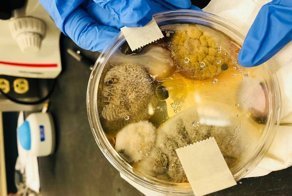
Американка показала ужасающую правду о сушилках для рук

12687
2
Он оказался тесно связан с другой проблемой членов современного общества.
Как выяснили ученые из Йельского университета (США), к алкоголизму вполне может привести недосып. Выводы они сделали после исследования, проведенного с участием 42 молодых людей, ранее злоупотреблявших алкоголем. Работой специалистов руководила доктор философии и доцент психиатрии Лиза Фусито.
Каждый участник эксперимента неделю отчитывался, сколько он выпивал спиртного, заполняя специальный дневник. Дополнительно к этому ученые измеряли продолжительность сна. Оказалось, что чем раньше люди вставали и чем короче был их сон, тем больше алкоголя они употребляли. Спиртное приводило к более позднему отходу ко сну по сравнению с ситуациями, когда люди мало пили или совсем отказались от вредного образа жизни.
По словам ученых, предварительные результаты показывают, насколько важно дальше изучать сон как один из факторов, влияющих на развитие алкоголизма у молодых людей. Новое исследование, вероятно, поможет улучшить сон, чтобы снизить риск обретения пагубной привычки.
По словам ученых, предварительные результаты показывают, насколько важно дальше изучать сон как один из факторов, влияющих на развитие алкоголизма у молодых людей. Новое исследование, вероятно, поможет улучшить сон, чтобы снизить риск обретения пагубной привычки.
Источник:
Ссылки по теме:
- Ученые выявили простой способ понравиться мужчине
- Ученые по зубам раскрыли тайну смерти Гитлера
- Американка показала ужасающую правду о сушилках для рук
- Моющие средства оказались слишком опасными
- Горячий чай способен довести до смертельной болезни
реклама

Человек встает рано, следовательно не высыпается. От этого испытывает дискомфорт, который от большого ума снимает бухлишком. Если британские ученые думают, что если человек не будет пить - то ему станет скучно и он ляжет спать в 9 вечера, то им стоит попробовать самим начать ложиться часа на 3-4 раньше комфортного для себя времени. И вставать соответственно, тоже. Результаты будут не менее увлекательны.
А вот говенную водку без хлебушка не втащишь - выблюешь, ненароком, ценный продукт.
Уже на пятом глотке каша от воды в спирте появляется...
Тут больше склонность к алкоголизму влияет на алкоголизм )
Сосед тоже спивается, хотя в ночь не работает... Кажется, я понимаю...